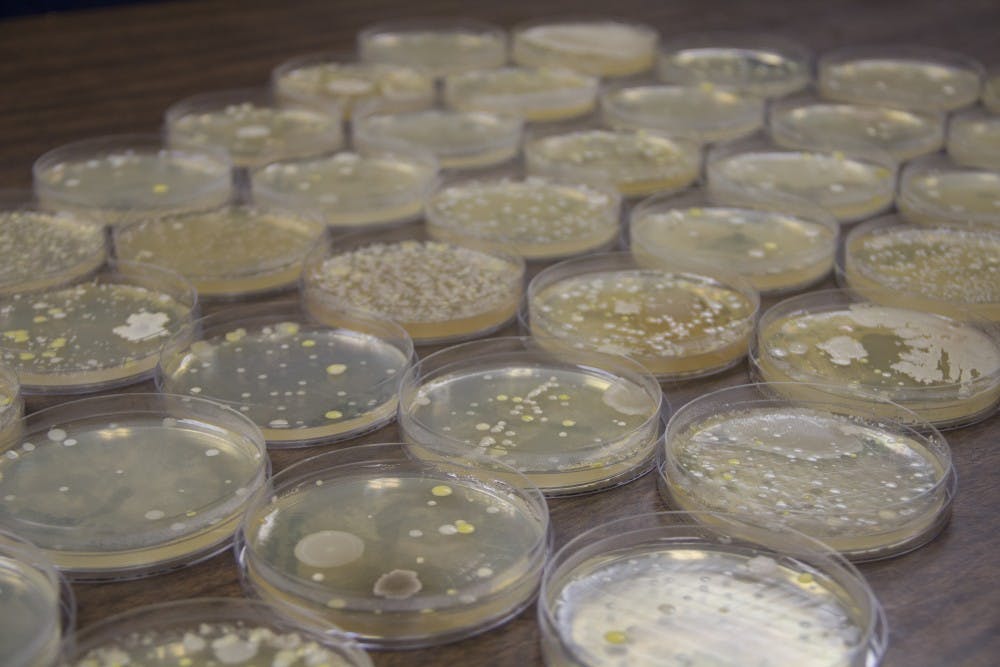
On March 7, The Spectrum swabbed 39 locations and commonly touched objects around North Campus to collect samples of microbes, which include bacteria, fungi, and mold. Samples from places like the Knox 20 table were identified as mold whereas items like a Putnam’s fork dispenser was relatively free of bacteria.

Gather ye rosebuds
By Allison Staebell | May 10, 2018In a very real way, I owe everything I have to Aaron Sorkin. For those of you who don’t know, Aaron Sorkin is a screenwriter and director famous for successes like “The West Wing,” “A Few Good Men” and “The Social Network.” He’s got two Golden Globes, an Oscar and five Emmys but for me, his gift to the world were his two lesser-known shows, “Sports Night” and “The Newsroom.” These shows changed my life.